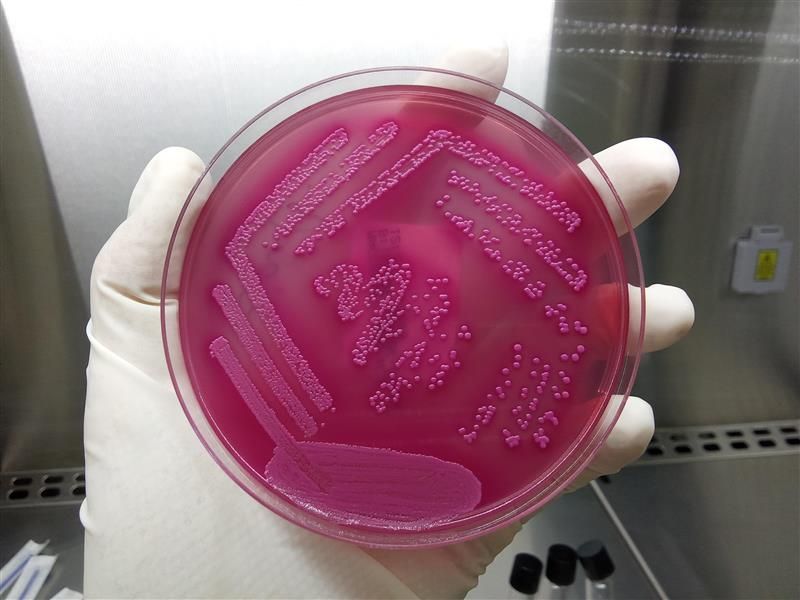

Zenit somos un laboratorio de análisis clínicos y ofrecemos servicios de diagnóstico veterinario.
Trabajamos por todo el territorio nacional, ofreciendo nuestros servicios. Diagnosticamos un amplio abanico de enfermedades para cubrir todas tus necesidades. Ofrecemos paneles diagnósticos a medida.
Entregamos los resultados el mismo día de recepción de las muestras.
Ofrecemos trazabilidad de las muestras desde el primer momento. Ponemos a tu disposición las últimas tecnologías en el campo del diagnóstico.
• Biología molecular
• Serología
• Microbiología
• Análisis de agua
(fisicoquímico y microbiológico)
Nuestro laboratorio a tu disposición
Selecciona la especie y rellena el formulario para el envío de muestras
Zenit news
Conoce el día a día y todas las novedades de nuestro laboratorio analítico